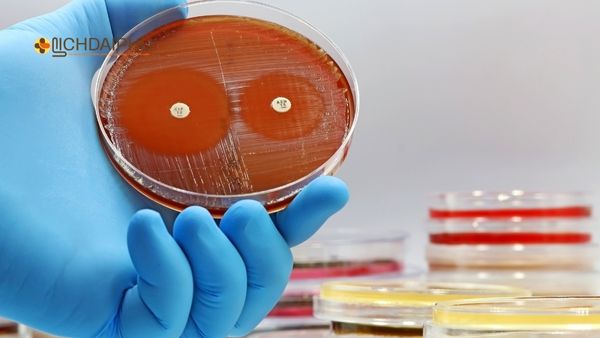
Vi khuẩn lậu kháng thuốc – Thách thức lớn trong điều trị bệnh lậu hiện nay Hình ảnh vi khuẩn lậu kháng thuốc được nuôi cấy trong phòng thí nghiệm, cho thấy khả năng đề kháng kháng sinh cao gây khó khăn trong điều trị bệnh lậu.

Bệnh lậu ở Hà Nội đang có xu hướng trẻ hóa nhanh chóng, khi ngày càng nhiều người trong độ tuổi 18–25 mắc bệnh. Nguyên nhân xuất phát từ lối sống tình dục phóng khoáng, thiếu kiến thức phòng bệnh và tâm lý chủ quan. Việc nhận biết sớm, điều trị đúng cách là chìa khóa để ngăn ngừa lây lan và biến chứng nguy hiểm.
- Dấu hiệu nhận biết bệnh lậu sớm cho người sống tại Hà Nội
- Địa chỉ chữa bệnh lậu uy tín tại Ba Đình – Hà Nội
- Top 10 địa chỉ khám chữa bệnh lậu uy tín ở Hà Nội

Bệnh lậu là gì?
Bệnh lậu là bệnh lây truyền qua đường tình dục do vi khuẩn Neisseria gonorrhoeae gây ra. Vi khuẩn này thường tấn công niêm mạc niệu đạo, âm đạo, cổ tử cung, hậu môn, họng hoặc mắt.
Bệnh có thể xuất hiện sau 2–5 ngày kể từ khi quan hệ không an toàn. Nếu không điều trị kịp thời, bệnh lậu có thể dẫn đến viêm nhiễm, vô sinh, thậm chí lây cho bạn tình.

Tại Hà Nội, do mật độ dân cư cao và đời sống xã hội cởi mở, bệnh lậu đang trở thành mối lo đáng báo động, đặc biệt trong giới trẻ.
Tình hình bệnh lậu ở Hà Nội hiện nay
Theo thống kê của các phòng khám và bệnh viện lớn, số ca mắc bệnh lậu ở Hà Nội tăng đều mỗi năm, trong đó nhóm tuổi 18–30 chiếm tỷ lệ cao nhất.
Một thực tế đáng lo ngại là nhiều ca phát hiện bệnh khi đã có biến chứng do phát hiện muộn hoặc tự ý mua thuốc điều trị.
Một số đặc điểm đáng chú ý:
-
Tỷ lệ bệnh nhân là sinh viên, nhân viên văn phòng, người độc thân tăng mạnh.
-
30–40% người mắc bệnh không biết mình bị nhiễm.
-
Tỷ lệ tái phát cao do vi khuẩn lậu kháng thuốc.
Hiện nay, nhiều phòng khám chữa bệnh lậu ở Hà Nội ghi nhận xu hướng “trẻ hóa” rõ rệt – một tín hiệu cảnh báo đáng lo cho cộng đồng.
Vì sao giới trẻ tại Hà Nội dễ mắc bệnh lậu?
Quan hệ tình dục sớm và thiếu an toàn
Giới trẻ ngày nay có đời sống tình dục sớm hơn, nhưng lại thiếu hiểu biết về bệnh lây qua đường tình dục. Nhiều người quan hệ mà không sử dụng bao cao su, hoặc dùng không đúng cách.
Quan hệ qua miệng hoặc hậu môn – hình thức phổ biến trong giới trẻ hiện đại – cũng là con đường lây nhiễm bệnh lậu ở Hà Nội nhanh chóng.
Ảnh hưởng từ môi trường xã hội và mạng xã hội
Sự phổ biến của ứng dụng hẹn hò, mạng xã hội giúp các mối quan hệ thân mật diễn ra nhanh và dễ dàng hơn. Điều này kéo theo việc quan hệ với nhiều bạn tình mà không có sự kiểm soát.
Tại các thành phố lớn như Hà Nội, đây là nguyên nhân khiến bệnh lậu lan truyền mạnh trong nhóm tuổi 20–30.
Thiếu kiến thức về sức khỏe sinh sản
Nhiều bạn trẻ ngại tìm hiểu hoặc cho rằng bệnh lậu chỉ gặp ở “người lớn tuổi” hay “gái mại dâm”. Thực tế, chỉ cần một lần quan hệ không an toàn, bạn đã có nguy cơ mắc bệnh.
Tâm lý e ngại, sợ khám bệnh
Giới trẻ thường ngại đi khám vì xấu hổ hoặc sợ bị phát hiện, khiến bệnh âm thầm phát triển. Một số tự mua thuốc kháng sinh, điều này khiến vi khuẩn lậu kháng thuốc, bệnh dai dẳng và tái phát.
Dấu hiệu nhận biết bệnh lậu ở Hà Nội sớm nhất
Ở nam giới:
-
Tiểu buốt, rát, chảy mủ màu vàng xanh ở đầu dương vật.
-
Đau tinh hoàn, sưng vùng bẹn.
-
Cảm giác nóng rát khi xuất tinh.

Ở nữ giới:
-
Khí hư nhiều, có mùi hôi, tiểu buốt, đau bụng dưới.
-
Chảy máu bất thường giữa kỳ kinh.
-
Đau khi quan hệ tình dục.
Dấu hiệu khác:
Nếu quan hệ qua miệng hoặc hậu môn, bệnh có thể gây:
-
Đau họng, sưng amidan, loét miệng.
-
Ngứa, rát hậu môn, chảy dịch.
Nếu bạn đang sống tại Hà Nội và có những triệu chứng trên, hãy đi xét nghiệm sớm tại cơ sở y tế chuyên khoa để xác định và điều trị kịp thời.
Biến chứng nguy hiểm của bệnh lậu nếu không điều trị
-
Ở nam giới: viêm tinh hoàn, tắc ống dẫn tinh, vô sinh.
-
Ở nữ giới: viêm vùng chậu, tắc vòi trứng, thai ngoài tử cung.
-
Ở cả hai giới: viêm khớp, viêm màng não, nhiễm trùng huyết.
-
Ở phụ nữ mang thai: lây cho con khi sinh, gây viêm kết mạc, mù lòa ở trẻ sơ sinh.
Những biến chứng này thường gặp ở người trẻ tại Hà Nội do phát hiện muộn hoặc điều trị sai cách.
Cách điều trị bệnh lậu ở Hà Nội hiện nay
Điều trị Tây y
Hiện nay, bệnh lậu thường được điều trị bằng kháng sinh đặc hiệu. Tuy nhiên, do vi khuẩn lậu ngày càng kháng thuốc, nhiều trường hợp cần kết hợp phác đồ mạnh hoặc tiêm trực tiếp.
Người bệnh không nên tự ý mua thuốc mà cần khám và xét nghiệm tại cơ sở y tế uy tín.
Điều trị bệnh lậu bằng Đông y
Tại Hà Nội, nhiều người lựa chọn điều trị bệnh lậu bằng thuốc Đông y vì:
-
Giúp thanh nhiệt, giải độc, tiêu viêm.
-
Tăng sức đề kháng, giảm tái phát.
-
Không gây tác dụng phụ.

Phương pháp này phù hợp cho người bị bệnh lậu mãn tính, tái phát nhiều lần hoặc không dung nạp thuốc kháng sinh.
Kết hợp lối sống lành mạnh
-
Kiêng quan hệ trong thời gian điều trị.
-
Uống nhiều nước, giữ vệ sinh vùng kín.
-
Không sử dụng rượu bia, chất kích thích.
Cách phòng ngừa bệnh lậu ở giới trẻ Hà Nội
-
Luôn dùng bao cao su khi quan hệ.
-
Hạn chế quan hệ với nhiều bạn tình.
-
Không quan hệ khi chưa biết rõ tình trạng sức khỏe của bạn tình.
-
Vệ sinh cơ thể sạch sẽ trước và sau khi quan hệ.
-
Khám sức khỏe định kỳ, đặc biệt khi có triệu chứng nghi ngờ.
-
Tuyên truyền giáo dục về bệnh lậu ở Hà Nội trong trường học, cộng đồng để nâng cao nhận thức.
Địa chỉ chữa bệnh lậu uy tín tại Hà Nội
Người bệnh nên lựa chọn phòng khám chuyên khoa nam học, phụ khoa hoặc y học cổ truyền uy tín, có xét nghiệm chuyên sâu và phác đồ điều trị rõ ràng.
Một số cơ sở được nhiều người tin tưởng:
-
Phòng khám tư nhân chuyên điều trị bệnh xã hội.
-
Cơ sở Đông y uy tín như Lịch Đại Phu, với bài thuốc viên hoàn Đông y chữa bệnh lậu đã được kiểm chứng an toàn và hiệu quả.

Kết luận
Bệnh lậu ở Hà Nội đang ngày càng trẻ hóa và lan nhanh trong giới trẻ. Nguyên nhân chính là lối sống tình dục thiếu an toàn, thiếu kiến thức và chủ quan trong việc khám bệnh.
Việc phát hiện sớm – điều trị đúng – phòng ngừa hiệu quả là cách duy nhất để kiểm soát bệnh.
Nếu bạn đang nghi ngờ mình mắc bệnh, hãy chủ động đến cơ sở y tế uy tín tại Hà Nội để được xét nghiệm và điều trị sớm.
Nếu bạn đang gặp các dấu hiệu nghi ngờ bệnh lậu hoặc muốn tìm hiểu về thuốc Đông y chữa bệnh lậu an toàn, hãy liên hệ Lịch Đại Phu để được tư vấn miễn phí.
📱 Zalo tư vấn:Nhấn để trò chuyện ngay
🌿 Điều trị sớm – Khỏi nhanh – Không tái phát
Lịch Đại Phu
